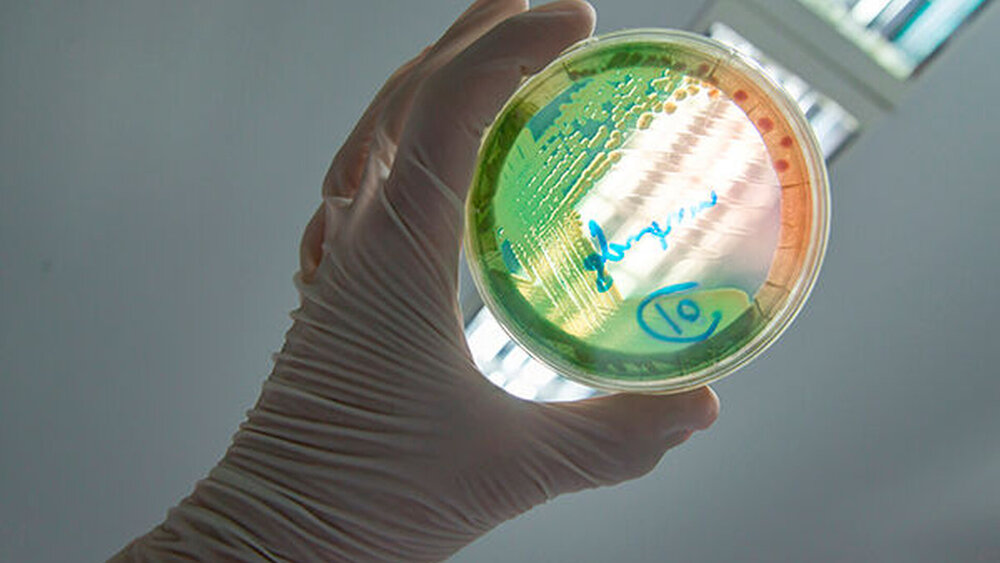

US-App spürt lokale Infektionen auf
Das Tool „Bugs + Drugs” speist sich aus anonymisierten ambulanten mikrobiologischen Daten. Ziel ist, Klinikern zu helfen, auf Basis von regionalen Fallzahlen zu Resistenzen und Empfindlichkeiten das bestgeeignetste Antibiotikum auszusuchen.
Die Funktion ist Teil der epocrates-App, die mehr als eine Million Ärzten, Krankenschwestern, Apothekern und andere medizinische Fachkräfte bei klinischen Entscheidungsfindungen unterstützt. Die App konzentriert sich dabei auf Arzneimittelverschreibungs- und Sicherheitsinformationen.
Das Tool listet laut US-Medienberichten viele Bakterien, die in Urin, Haut und anderen Probentypen vorkommen und zeigt die berichtete Häufigkeit ihres Auftretens nach US-Postleitzahlbereichen. Für jeden Organismus schlägt das Tool relevante Antibiotika-Optionen vor mit entsprechenden Informationen zu Empfindlichkeiten, Dosierungen, Details zu Arzneimittelwechselwirkungen, Sicherheitsinformationen sowie berichteten Resistenzen.
Daten stammen aus anonymisierten Laborbefunden
„In einer Zeit, in der antimikrobielle Resistenzen zunehmen, füllt Bugs + Drugs eine große Lücke im ambulanten Bereich. In der Vergangenheit mussten Kliniker fundierte Vermutungen über die Prävalenz verschiedener Bakterien anstellen und darüber, ob diese Organismen anfällig oder resistent gegen verschiedene Antibiotika sind”, erklärt MD Anne Meneghetti von epokrates.
Mit Bugs + Drugs hätten Kliniker jetzt ein innovatives, digitales Tool, das lokalisierte Suszeptibilitätsdaten bietet, um fundierte Point-of-Care-Entscheidungen sicher zu treffen. Die Daten für das Tool stammen aus anonymisierten mikrobiologischen Daten und cloudbasierten elektronischen Patientenakten, heißt es.
Laut der US-Gesundheitsbehörde CDC gab es vor der Pandemie in den USA jährlich 2,8 Millionen Fälle von Infektionen mit antibiotikaresistenten Bakterien („Superbugs”), die zu mehr als 35.000 Todesfällen pro Jahr führten.
Ein CDC-Sonderbericht zeigt nun, dass es in den ersten Pandemiejahren zu einem immens erhöhten Antibiotikaeinsatz und gleichzeitig weniger Präventionsmaßnahmen und Datenlücken in der Nachverfolgung von Resistenzen kam. Von den 18 Krankheitserregern, die im CDC-Bericht 2019 als Antibiotikaresistenzbedrohungen aufgeführt sind, fehlen für neun aktualisierte Daten – und für acht Erreger wurde ein Anstieg der gemeldeten resistenten Infektionen um bis zu 78 Prozent verzeichnet, berichtet der Branchendienst Fierce Healthcare .
75 Prozent der US-Patienten mit schwerem COVID erhielten Antibiotika
„Stationär erhielten viele Patienten mit Fieber, Lungenentzündung und schwerem COVID, drei Viertel dieser Patienten Antibiotika, aber jetzt wissen wir, dass nur neun Prozent eine bakterielle Infektion hatten, die auf Antibiotika hätte ansprechen können”, sagt Meneghetti. Ob es im ambulanten Bereich ähnliche Vergabesteigerungen gegeben hat, weiß die Medizinerin nicht, weil entsprechende Daten fehlen.
Um der wachsenden Bedrohung durch Resistenzen zu begegnen, werden in den USA bei den Verschreibungsentscheidungen lokale Resistenz- und Empfindlichkeitsmuster einbezogen. Stationäre Einrichtungen veröffentlichen in der Regel dazu Empfindlichkeitsdaten, die ihr Krankenhaus betreffen.
Daten zur Empfindlichkeit gegenüber Antibiotika wurden bislang jedoch nicht umfassend aggregiert oder ambulant öffentlich zugänglich gemacht, teilt epocrates mit. Ohne solche Daten müssten sich Kliniker auf ihr Erfahrungswissen verlassen, um die Auswahl des zu verschreibenden Antibiotikums zu treffen. Entscheidungen, die für einzelne Patienten getroffen werden, hätten jedoch immer das Potenzial, bakterielle Resistenztrends voranzutreiben.